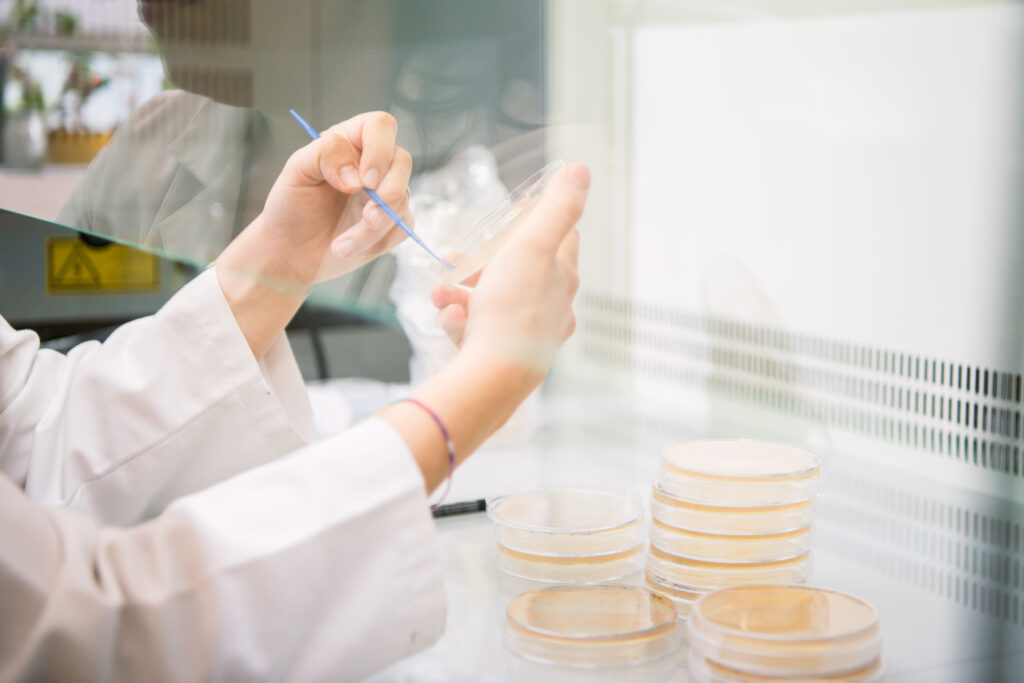

En Agrolac Andina estamos comprometidos con la excelencia, la seguridad y la transparencia. Trabajamos con rigor técnico y mejoramiento continuo para estar a la altura de las mejores prácticas del sector.
Con el objetivo de maximizar la satisfacción de nuestros clientes, operamos con un sistema de gestión robusto que asegura la calidad, la seguridad y la trazabilidad en nuestros procesos. En Colombia, aplicamos una metodología de trabajo alineada con los estándares ISO 9001 (gestión de calidad), e incorporamos criterios de ISO 14001 (gestión ambiental) y ISO 50001 (gestión de la energía), como parte de nuestra forma de operar y de nuestro compromiso con la sostenibilidad.
Estamos inscritos ante el Instituto Colombiano Agropecuario (ICA) y cumplimos la normativa vigente aplicable a la comercialización y distribución de insumos agrícolas. Esto incluye el manejo adecuado de documentación técnica (fichas y hojas de seguridad), buenas prácticas de almacenamiento y manejo, y controles internos orientados a garantizar un suministro confiable y responsable.
En gestión ambiental, promovemos la disposición responsable de envases y empaques mediante la vinculación a un programa posconsumo autorizado en Colombia, orientado a la recolección y gestión adecuada de envases de insumos agrícolas. Con esto fortalecemos la trazabilidad y el cumplimiento en toda la cadena.
Además, contamos con el respaldo de International Chemistry Associates (Grupo ICA), holding internacional que integra compañías con trayectoria en el sector agrícola. Esa experiencia y capacidad técnica del grupo nos permite transferir metodologías, criterios y buenas prácticas que elevan el estándar de nuestra operación en Colombia.